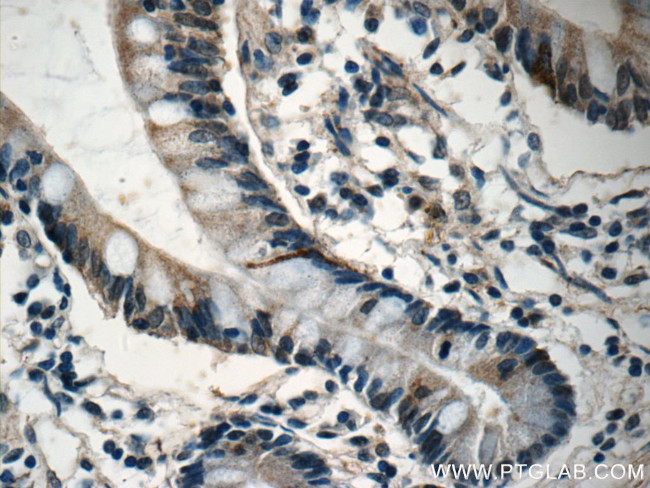
DNAH6 Antibody in Immunohistochemistry (Paraffin) (IHC (P))

Search
Proteintech
DNAH6 Polyclonal Antibody
{{$productOrderCtrl.translations['antibody.pdp.commerceCard.promotion.promotions']}}
{{$productOrderCtrl.translations['antibody.pdp.commerceCard.promotion.viewpromo']}}
{{$productOrderCtrl.translations['antibody.pdp.commerceCard.promotion.promocode']}}: {{promo.promoCode}} {{promo.promoTitle}} {{promo.promoDescription}}. {{$productOrderCtrl.translations['antibody.pdp.commerceCard.promotion.learnmore']}}
产品信息
18080-1-AP
种属反应
宿主/亚型
分类
类型
抗原
偶联物
形式
浓度
规格
纯化类型
保存液
内含物
保存条件
运输条件
产品详细信息
This antibody is specific to DNAH6.
Immunogen sequence: MTYTEQASK RHYCMRLTCF IRLNDYLIEN TMHILTVNAV NSLLNHLTDK LKRTPSADVI QKWITEEKPE VPDKKGTLMV EKQEEDESLI PMFLTELMLT VQSLLFEPSL EDFLDGILGA VNHCQNTVLS VPNLVPDSYF DAFTSPYINN KLEGKTCGTG PSLAAVFEDD KNFHTIISQI KETIQAAFES ARIYAATFEK FQIFFKENES LDLQALKLQE PDINFFSEQL EKYHKQHKDA VALRPTRNVG LLLIDTRLLR EKLIPSPLRC LEVLNFMLPR QSKKKVDAII FEAQDAEYKL EFVPTTTTEY VHSLLFLDEI QERIESLEDE GNIVTQMYKL MEQYQVPTPP EDFAVFATMK PSIVAVRNAI DKSVGDRESS IKQFCVHLGS DLEELNNEVN EVKLQAQVS (1-408 aa encoded by BC104884 )
靶标信息
DNAH6 is a protein coding gene.
仅用于科研。不用于诊断过程。未经明确授权不得转售。
生物信息学
蛋白别名: Axonemal beta dynein heavy chain 6; axonemal dynein heavy chain; Ciliary dynein heavy chain 6; Dynein axonemal heavy chain 6; dynein heavy chain 6, axonemal; dynein heavy chain-like 1; dynein, axon, heavy chain 6; dynein, axonemal, heavy polypeptide 6; unnamed protein product
基因别名: 9830168K20; A730004I20Rik; axo a; DNAH6; DNAHC6; DNHL1; HL-2; HL2; KIAA1697; mdhc6; mKIAA1697
UniProt ID: (Human) Q9C0G6
Entrez Gene ID: (Human) 1768, (Mouse) 330355, (Rat) 117250